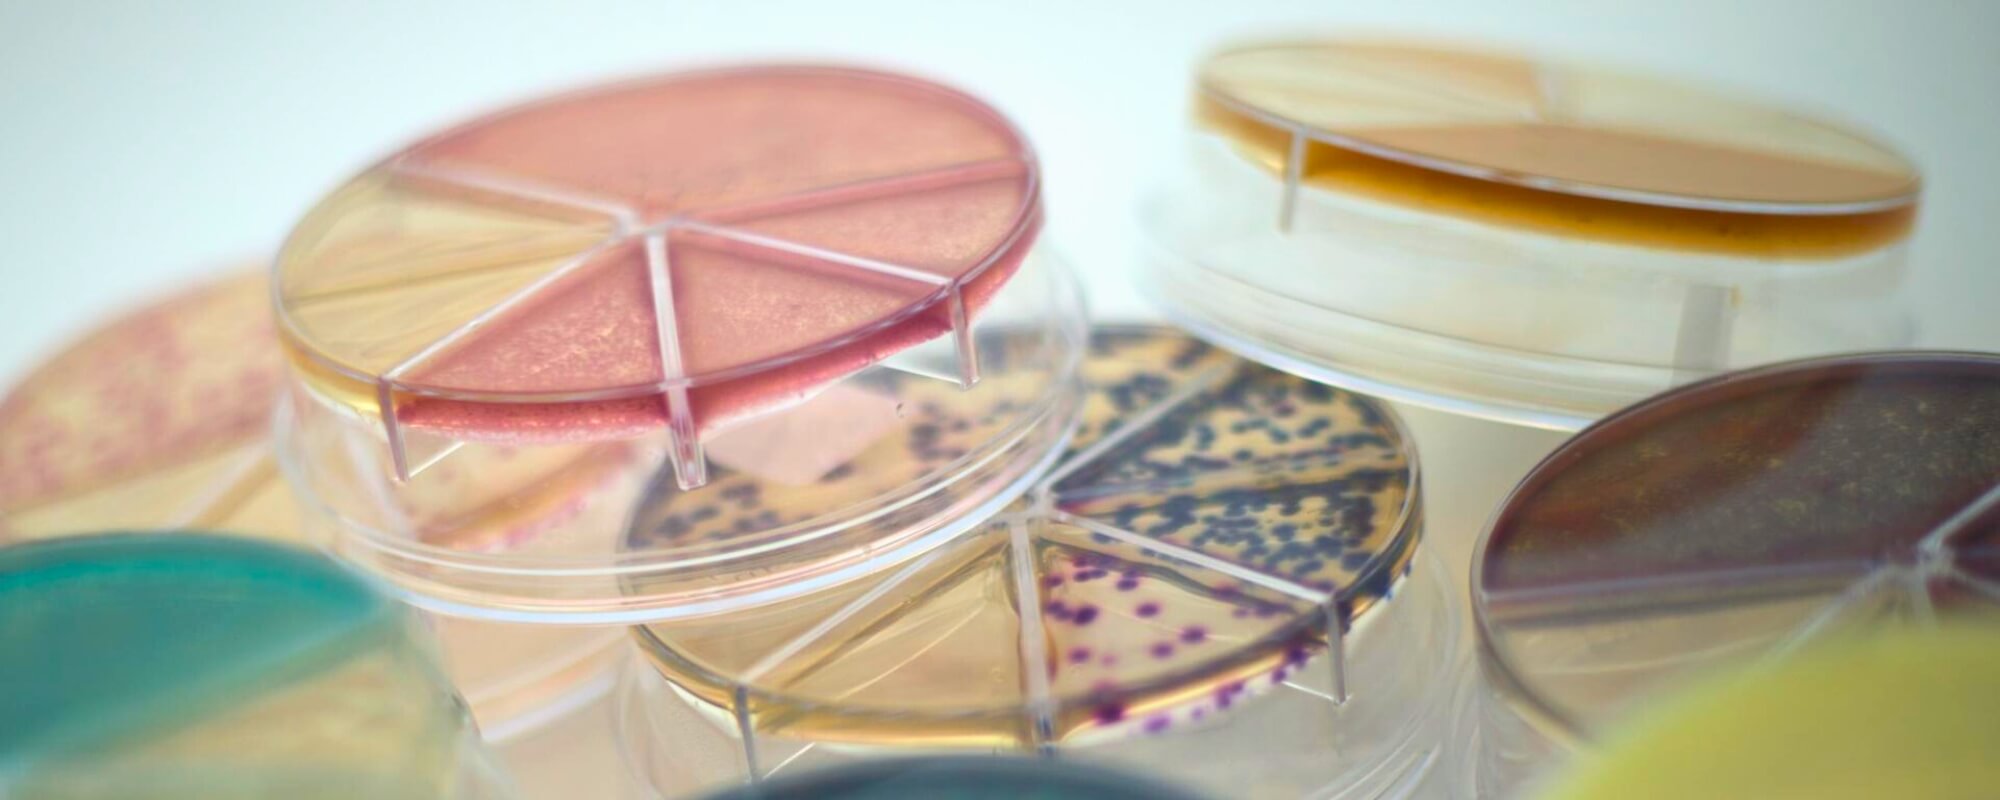

| Fragt | |||
| Total Moms |
|
||
| Total inkl. moms |
MANUALER
Find manualer og quickguides til korrekt brug af dit udstyr til laboratoriet og klinikken. Vi hjælper dig gerne, hvis du har spørgsmål på tlf. nr. 86 21 08 00 eller salg@hounisen.com. Kontakt os alle hverdage kl. 8.00-16.00, fredage til kl. 15.30.
Populære manualer

Manualer
DiaSpect quickguide
Læs mere
DiaSpect™ tilbyder hurtige og pålidelige målinger af hæmoglobinindhold i en lille blodprøve. Kom godt i gang med DiaSpect™-apparatet med denne quickguide.

Manualer
Sådan bruger du Flexicult® urinkit
Læs mere
Brug Flexicult® Urinkit til hurtig og simpel diagnosticering af urinvejsinfektioner. Se hvordan i denne guide med tilhørende videoer fra SSI Diagnostica.


Manualer
Sådan bruger du Urin-Monovette®
Læs mere
Med Urin-Monovette® fra SARSTEDT er du sikret et hygiejnisk, lukket og kanylefrit opsamlingssystem til urinprøver. Det innovative NFT-system kombinerer et gennemtænkt des...


Manualer
Installation af EDAN SE-1515 software via link
Læs mere
Følg denne vejledning til installation af softwaren SE-1515 PC ECG Workstation, hvis du ikke har mulighed for at benytte den medfølgende CD.

Du kunne også være interesseret i...







